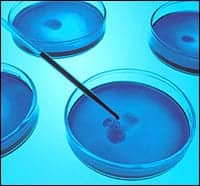

![]() |
“Middleware is traditionally defined as being in the middle of lab instruments and the LIS,” says Gregory Vail, president of Data Innovations, South Burlington, Vt. “But I prefer to think of it as in the middle of lab operations.”
Rodney Day, MSMT (ASCP), director of informatics and laboratory consulting services with Siemens Medical Diagnostic Solutions, Malvern, Pa, agrees that a broader definition is beginning to take hold. “Within the past 45 years, middleware has taken on an expanded role,” he says, “and lab managers are beginning to think of middleware as anything that does not reside on the instruments or the LIS.”
Middleware’s primary role is still to connect analyzers and the LIS, but it is also capable of much more functionality than connectivity. Middleware software can assist with auto-verification, specimen storage and retrieval, and quality control. Compliance, trending, and reporting can be handled through middleware, without requiring a programmer. Significant time can be saved, increasing laboratory efficiency.
New trends in quality control, including instrument diagnostics and instrument console control, will lead to greater efficiencies, increasing the software’s value. Returns on investment can be realized within months.
Middleware, however, is not meant to replace any system in the laboratory, particularly the LIS. Rather, the two complement each other.
“The other important thing to note when defining middleware is what it is not,” Vail says. “Middleware is not the next LIS. Middleware came about to fill in the gaps of the LIS and is meant as a value enhancer.”
Meeting Unmet Needs
“Middleware can provide data management tools for the lab that might not be available or might be difficult to use in the existing LIS or instrumentation, filling a gap or unmet need,” concurs Mike Flanagan, director of global marketing for informatics products at Dade Behring, Deerfield, Ill. As an example, he notes that specimen storage and retrieval functions can reduce the time it takes to locate and retrieve a specimen.
Some middleware can provide a sample’s location by refrigerator, rack, and position, saving a technologist the time it would normally take to physically find the specimen.
“We are seeing a more than 60% reduction in the time devoted to tracking specimens,” says Jon Wearly, product manager for information technology (IT) systems and solutions with Roche Diagnostics, Indianapolis. “In its advanced format, middleware helps to create efficiencies throughout the entire workflow,” he adds.
![]() |
Middleware automates some of the more mundane but labor-intensive tasks in the lab, freeing technologists to concentrate on more critical results and complex tests.
Auto-verification is one such area. An LIS may offer this capability, but to actually use it requires someone with programming knowledge. Middleware can eliminate this need, providing rules-making capabilities, often reduced to Boolean logic.
“Many LIS systems require a more technical user [to create rules], but middleware software uses a simpler Boolean logic—if/then logic. You don’t need JavaScript, but you can use drop-down menus,” says Wearly, who cites auto-verification as the primary reason he sees laboratories investing in middleware.
“Middleware can provide a standardized decision-making process to ensure patient safety,” says Al Akiyama, product manager, information systems, at Beckman Coulter, Fullerton, Calif. Technologists can be alerted to critical results with a pop-up window. The next steps are user definable and can be done by physician or test.” Flexibility in rules making is key.
With middleware as the primary rules station, bad data is prevented from getting into the LIS. “Once a sample gets into an LIS, it can be difficult to manipulate data,” says Ronald J Rossman, president of Medicus Middleware, Nashville, Tenn.
Middleware can specifically assist with quality control, filling in the information gaps that are not stored on the LIS. “The LIS doesn’t really keep all the information from the instrument,” Day says. “Labs need something to help keep track of the audit trail so they no longer have to keep reams of manual records and paper copies printed out of every instrument. It permits real-time control.”
Middleware also allows quality control to be administered from one central station rather than from each individual analyzer. Some systems can go even further, keeping track of reagent supply or other consumable life spans to alert laboratorians when new supplies are needed on an instrument before they run out.
In addition to linking the LIS to a lab’s instruments, middleware can also link separate laboratories; many integrated health networks are using the software to fulfill this function. Others are using it to perform outreach.
“Middleware can allow a general or university hospital to hook up outreach programs so they can be reference labs to the community and expand their business beyond the hospital and their traditional business base,” says Hunter Bagwell, manager of implementation consulting services with Data Innovations, .
Middleware gives laboratories greater control of their business, reducing their reliance on the IT department and their LIS. “The LIS life cycle tends to be 12 years, some as long as 17, so it does not get replaced very often,” Day says. “Many new features are not in legacy LIS, and middleware fills in those inadequacies.”
The Value Equation
Middleware fills in the gaps comparatively cheaply. “Interfaces with the LIS can be quite expensive, from $5,000 to $20,000, which can get quite costly when connecting to four or five analyzers,” says Medicus’ Rossman. “Middleware decreases that cost because it requires just one LIS interface.”
The cost of middleware has a wide range. “The type of investment for middleware falls into three areas: the upfront purchase of the system; the cost to implement the system; and the ongoing support, operation, and maintenance of the system,” says Dade Behring’s Flanagan.
Prices can range from $5,0000 to $150,000. The exact cost will depend on the features of the system—how many instruments are interfaced and how many options will be included. Medicus offers its middleware for $7,500, which includes six interfaces. Many other systems charge for interfaces separately.
Navigating the Middleware Mall
Larger labs are usually early adopters of technology, and many already have middleware systems, according to Jon Wearly, product manager for IT (information technology) systems and solutions with Roche Diagnostics, Indianapolis. But midsize labs are still investing heavily. “The trend started early last year, and we expect to see most middleware purchased in the market in 2007 and into 2008,” Wearly says.
The first thing these labs should consider as they begin their shopping is their LIS. “Labs need to understand the strengths and weaknesses of their LIS, and current instrumentation, and make sure the middleware they buy addresses the gaps they have,” says Mike Flanagan, director of global marketing for informatics products at Dade Behring, Deerfield, Ill.
They should also take into account their future. Buyers should consider scalability as well as the cost to add additional interfaces and functions. “It’s best to begin with the end in mind and work backwards,” says Hunter Bagwell, manager of implementation consulting services, Data Innovations, South Burlington, Vt.
With the needed features identified, a laboratory can then compare the different systems. However, laboratories should also consider the enterprise. While each laboratory may require a different function, if the facilities within one system choose different software, they may have to create interfaces later. “You want to avoid the hodgepodge scenario that the middleware is trying to alleviate,” Bagwell says.
The vendor matters too. Laboratories should consider a company’s history and reputation as well as experience. Service contracts and training options should be factored into cost, as well as the product’s functional features. References from other biomeds are always helpful, and vendor references should always be checked.
This can provide information about how a system really operates. “Many labs have experienced problems with slow systems,” says Rodney Day, MSMT(ASCP), director of informatics and laboratory consulting services, Siemens Medical Diagnostic Solutions, Malvern, Pa, who advises that buyers look at the hardware that will run the systems as well.
The beauty of middleware is that it is very often scalable, and laboratories can purchase systems tailored to their needs. They just need to know what those needs are.
“Price often depends on the complexity and size of the system,” Wearly says. “Middleware has a little more à la carte functionality in the way it is tailored to the customer’s size and specifics.” This means laboratories can maximize their capital investment, paying for functions they will use.
They can also maximize their returns by taking advantage of functionality. “ROI [return on investment] depends on a number of factors, including how quickly the laboratory can adapt to the middleware system,” Flanagan says. “For example, labs may start slowly with auto-verification, implementing a few tests and saving just a few minutes, and building on that over time. But it is these value-added capabilities that will lead to cost savings.”
Bagwell notes that a laboratory can implement a Data Innovations stand-alone storage-and-retrieval system for $10,000, and see the return in as little as 3 months.
Siemens’ Day notes that he hasn’t seen a laboratory take more than 1 year to achieve a return on the investment.
Quality Control
As middleware developers continue to expand functionality, the systems will provide even greater value. Quality control is one area middleware is just beginning to penetrate. In addition to maintaining QC of specimens through auto-verification, some middleware systems can also maintain QC for instruments, including centrifuges, eye washes, and refrigerators. They can track reagent consumption and provide QC in real time.
Developers are integrating quality control into the auto-verification process to verify results as they come off the instrument and to make sure the instruments stay within control. Some systems adhere to QC schedules, for instance not allowing specimen testing until controls have been run. Others can verify data with third-party QC devices before sending information on to the LIS.
Storage of this data, combined with reporting features, makes documentation for regulatory purposes much easier, particularly with the advent of surprise inspections.
“A maintenance module can provide the online electronic record for all maintenance,” Bagwell says.
Reporting features are also expected to expand as middleware evolves. “Laboratorians will look for trends and solutions using ad hoc reporting rather than traditional investigative means,” Bagwell says.
Middleware will continue to improve its auto-verification capabilities, as well as incorporate new, convenient features, such as automatic log-on and log-off. Web functionality will permit remote access to data, allowing laboratories to more easily communicate with physicians and other labs.
Middleware will also follow automation into blood banking and molecular testing. Data Innovations recently announced that the FDA had granted 510(k) clearance for its system for use in blood banking.
“There is a tremendous amount of analytical data that comes from these molecular instruments, and laboratories have to have something that helps to take that mass of data and distill it down to useful information for physician and patient. Middleware will play a strong role,” predicts Siemens’ Day.
Many companies will be driven by the demands of their customers. Vail notes that Data Innovations has a list of requests still to be implemented. And of course, as laboratories change their businesses, new demands will arise.
![]() |
| Want to read more? Search for “middleware” in our online archives. |
“These questions are at the forefront of laboratorians’ minds as they ponder middleware,” says Jay Jones, PhD, DABCC, director of chemistry and regional laboratories for Geisinger Health System, Danville, Pa. “This is just the beginning. IT will dominate our future — EMRs, remote results reporting, and a flexible tool like middleware will be exercised greatly.”
In other words, it’s clear that middleware will be right in the middle of lab operations.
Renee DiIulio is a contributing writer for CLP. For more information, contact .